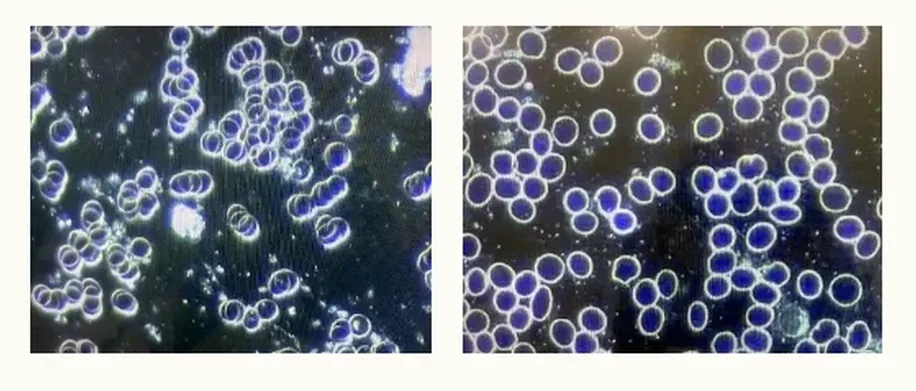

Έρευνα δείχνει ότι η θεραπεία με Όζον αντιστρέφει τους θρόμβους αίματος και αφαιρεί την τοξική ακίδα που προκαλούν τα εμβόλια!

Ένα από τα μεγαλύτερα προβλήματα που έχουν παρατηρηθεί σε ό,τι αφορά τα εμβόλια κατά του κορωνοϊού, είναι το γεγονός ότι προκαλούν σοβαρή πήξη του αίματος και θρόμβους σε μερικούς ανθρώπους. Μια μελέτη δείχνει ότι ίσως να υπάρχει τρόπος να καταπολεμηθεί αυτή η βλάβη χρησιμοποιώντας τη θεραπεία με όζον.
Ο Δρ Thomas E. Levy, MD, JD, δημοσίευσε ένα άρθρο στο Orthomolecular Medicine News Service (OMNS) εξηγώντας πώς οι θεραπείες με όζον είναι σε θέση να «ακυρώσουν την τοξική πρωτεΐνη ακίδας» που εισάγεται στο σώμα μας απο τα εμβόλια. Τα στοιχεία που παρουσιάζει στις εικόνες είναι όντως εκπληκτικά:
Όπως φαίνεται στην πρώτη εικόνα, τα αιμοσφαίρια του ασθενούς είναι όλα θρομβωμένα μετά από τα εμβόλια. Η δεύτερη εικόνα, συγκριτικά, δείχνει αυτά τα ίδια αιμοσφαίρια στην κανονική τους κατάσταση μετά τη θεραπεία με όζον. Οι δύο πρώτες εικόνες αφορούν αιμοσφαίρια που αναλύθηκαν από μια 62χρονη γυναίκα που της έκαναν την ένεση.
Οι δεύτερες εικόνες αιμοσφαιρίων είναι από άλλο ασθενή. Σε αυτήν την περίπτωση, ένας νεαρός άνδρας έλαβε ένα εμβόλιο κατά του Covid και 15 ημέρες αργότερα ανέπτυξε αυτό που φαίνεται στην πρώτη εικόνα: σοβαρή πήξη του αίματος που συνηθίζεται στους νέους να είναι ακόμη πιο ανησυχητική. Αφού έλαβε οζονοθεραπεία, τα αιμοσφαίρια του “κανονικοποιήθηκαν” και έγιναν αυτό που απεικονίζεται στη δεύτερη εικόνα.

Σχετικό: Έρευνα Ιταλών Γιατρών βρήκε ανωμαλίες στο αίμα εμβολιασμένων με Covid – τους φάνηκε τόσο περίεργο που ειδοποίησαν την ιατρική κοινότητα! (βίντεο)
Ένας τρίτος ενήλικας που έλαβε τον εμβολιασμό 30 ημέρες νωρίτερα είχε επίσης σοβαρό σχηματισμό rouleaux κατά την εξέταση με μικροσκόπιο σκοτεινού πεδίου, και αυτό επίσης επιλύθηκε πλήρως μετά την έγχυση οζονισμένου φυσιολογικού ορού που ακολουθήθηκε από την έγχυση βιταμίνης C. Αξίζει να σημειωθεί ότι παρόμοια μη φυσιολογικά ευρήματα μικροσκοπίας σκοτεινού πεδίου βρέθηκαν σε άτομα μετά από εμβολιασμούς για τον COVID-19 με Pfizer, Moderna ή Johnson & Johnson.
«Υπό συνθήκες φλεγμονής και συστηματικά αυξημένου οξειδωτικού στρες, τα ερυθρά αιμοσφαίρια μπορούν να θρομβόσουν σε διαφορετικό βαθμό, μερικές φορές κολλώντας μεταξύ τους σαν στοίβες με διακλάδωση», γράφει ο Levy.
«Αυτό είναι γνωστό ως σχηματισμός rouleaux των ερυθρών αιμοσφαιρίων. Όταν αυτός ο σχηματισμός rouleaux είναι έντονος, παρατηρείται αυξημένο ιξώδες (πάχος) αίματος και υπάρχει αυξημένη αντίσταση στην κανονική ροή του αίματος, ειδικά στη μικροκυκλοφορία.»
Δείτε περισσότερα στο http://orthomolecular.org/resources/omns/v17n24.shtml















